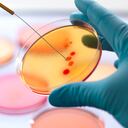
Scientist innoculating a series of agar plates with bacteria, Property Release 1/13 Model Release 2/13.

Un estudio publicado en la revista The Journal of Clinical Investigation indicó que durante el embarazo la placenta ejerce un efecto protector contra el coronavirus. Se trata de una investigación llevada a cabo por investigadores del Hospital Universitario Vall d’Hebron (VHIO) de Barcelona (España), del Hospital Policlínico de Milán (Italia) y de la Universidad de Basilea (Suiza).
De acuerdo con los investigadores, el estudio adelantado tenía como objetivo analizar el impacto de la covid-19 sobre la fisiopatología de la placenta y sus consecuencias sobre el recién nacido, por lo que llevaron a cabo un análisis clínico, morfológico y molecular de una cohorte de 37 mujeres embarazadas que dieron a luz durante la primera ola de la pandemia en Italia.
Durante ese período, los investigadores establecieron que 21 de las mujeres embarazadas que tenían covid-19, aunque el virus hubiese podido infectar a las placentas, no hallaron evidencia de la transmisión en ninguno de los recién nacidos.
“Hemos constatado que, aunque el virus puede infectar la placenta, en ningún caso se produjo una transmisión vertical de la madre al recién nacido, lo que apunta a que la placenta puede ser una barrera materno-neonatal eficaz contra el virus”, dijo al respecto Paolo Nuciforo, jefe del grupo de Oncología Molecular del VHIO.
A su vez, los investigadores identificaron que cuando la carga viral en la placenta era muy elevada, aunque sigue actuando como una barrera, puede verse afectada e influir en el desarrollo del neonato.

Teniendo en cuenta lo anterior, Joan Seoane, director del Programa de Investigación Preclínica y Translacional del VHIO y coautor del estudio, explicó que “ocasionalmente la covid-19 puede infectar masivamente a las células de la placenta y determinar su muerte”.
Los investigadores también hallaron que la respuesta inflamatoria es similar a la que se observa en algunos tumores. “Si entendemos este sistema inflamatorio seremos capaces de desarrollar nuevos tratamientos”, agregó Seoane.
Vale destacar que en julio del año pasado fue publicado en la revista científica Nature un estudio de médicos franceses, que podría contradecir el anterior. En ese, los galenos habían documentado que “la transmisión (del virus) de madre a feto es posible a través de la placenta durante las últimas semanas de embarazo”.

Vacunas contra la covid-19 se probarán en recién nacidos, niños y mujeres embarazadas
A medida que la vacunación masiva avanza en el mundo y que se ha encontrado que todas las dosis aprobadas tienen éxito en reducir los índices de infección de la covid-19, las farmacéuticas han tomado decisiones para sumar más grupos a la inmunización.
En este sentido, AstraZeneca confirmó este domingo que ya tienen programados tests para la aplicación de su vacuna en niños y potencialmente en recién nacidos.

Según el laboratorio, se tomó la decisión de expandir sus pruebas a niños de hasta seis años. A la par, la firma Janssen, cuya casa matriz es Johnson & Johnson, estaría evaluando avanzar con las pruebas de vacunación en recién nacidos y hasta mujeres embarazadas.
En ambos casos, si los testeos muestran resultados positivos en la reducción del contagio, se continuará con la aplicación a grupos de ciudadanos más grandes.
